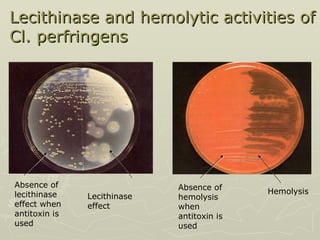
Lecithinase and hemolytic activities of Cl. perfringens Absence of lecithinase effect when antitoxin is used  Hemolysis  Lecithinase effect   Absence of hemolysis when antitoxin is used

The document discusses several Clostridium species that are important anaerobic pathogens. It describes Clostridium perfringens, the main cause of gas gangrene, and its virulence factors including alpha toxin. It also discusses Clostridium botulinum, which causes botulism through its powerful neurotoxin, and Clostridium tetani, which causes tetanus through its potent exotoxin. Clostridium difficile is noted as the cause of antibiotic-associated colitis.